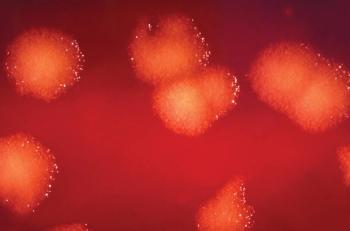

Calculating Return-to-Work COVID-19 Policies Is a Balancing Act for Hospitals
Investigators concluded that HCPs can safely return to work after 7 days of quarantine if they test negative for COVID-19 on days 5 to 7.
Frank Diamond has been with Infection Control Today since November 2019. He has more than 30 years of experience working for magazines, newspapers, and television news.

Investigators concluded that HCPs can safely return to work after 7 days of quarantine if they test negative for COVID-19 on days 5 to 7.
Bug of the Month helps educate readers about existing and emerging pathogens of clinical importance in healthcare facilities today.

IPs in the VA system aim their infection prevention sights on most areas of care: acute care, nursing homes, palliative, mental health. They track infections differently. In addition, the VA acts as a testing ground for IP innovations.

Long COVID appears to be worsening the labor shortage in the United States, and the health care industry—which has lost 20% of workers over the pandemic—could be particularly hard hit.

Lisa Waldowski, DNP, RN, CIC, of Kaiser Permanente: “There will always be a role for infection preventionists. I don’t worry about job security, so to speak. There are so many elements within infection prevention and control.”

There’s a long way to go before the industry recovers from the mass worker exodus from health care during the COVID-19 pandemic. Infection prevention especially faces daunting challenges.

A CDC program examines wastewater to get a jump on COVID-19 eruptions, and also to detect new variants, some of which may have been hatched in animals.

Jamie Seltzer: “We have so much history—recent history as well as 100 years ago—to tell us that it would be incredibly unusual and atypical if SARS-CoV-2 were the only viral infection that did not lead to post-viral complications.”

A public/private enterprise taps into the entrepreneurial urge that will hopefully help the United States avoid the disastrous shortages of personal protective equipment that deviled the health care system in the first months of the COVID-19 pandemic.

Beneficiaries in both original Medicare and Medicare Advantage plans will be able to obtain 8 free at-home COVID-19 tests a month.

Individuals who’ve been vaccinated and those vaccinated who’ve also gotten a booster are less likely to become infected by either Omicron or stealth Omicron, the study states.

ICU nurses, more than other clinicians, because they have the most interaction with patients. Non-clinical workers because they may not be knowledgeable enough about mitigation methods, a study states.

Initial data suggest that it appears to be more infectious than even the highly infectious original Omicron variant.

Long COVID’s symptoms seem to match those of myalgic encephalomyelitis/chronic fatigue syndrome (ME/CFS), a condition that millions have suffered from for decades.

Reinfections among study participants most likely occurred outside the hospital setting where workers might let their guard down and not practice nonpharmaceutical mitigation efforts against SARS-CoV-2.

Moves by the FDA and NIH to revise treatment guidelines run up against a system of testing for COVID-19 that faces logistical hurdles.

Linda Spaulding, a member of ICT®’s Editorial Advisory Board, and a consultant, plans to fly out to Hawaii later this week to advise her LTCF clients in that state about how best to get through the current surge.

Some experts see Omicron starting to peak in the U.S., and “normal” may soon return. In the meantime, unfortunately, be prepared for a rough month or so.

There’s not much IPs can do to help nurses who battle the Omicron surge except urge hospital administrators to listen to their grievances.

COVID-19 seems to be present in many white-tail deer. The danger posed by that includes COVID-19 mutating into a new variant that reinfects humans, says a study.

Infection prevention and control experts offer their peers advice on how to handle overcrowding at hospitals and what to do about masking.

Health care workers who work at facilities that care for patients who have Medicare or Medicaid must get the COVID-19 vaccine.

Infection preventionists and other health care professionals once again on the frontlines battling a COVID-19 surge need be wary of “mild” symptoms that could haunt them in the long run.

Omicron and an ample supply of N95s and KN95s might lead the CDC to change masking recommendations for the public this week to say that individuals should wear those masks.

Before COVID-19, the infection prevention department got a median of 71 calls a month. When COVID-19 struck, that rose to 368 a month, with 50% of calls concerning isolation precautions, the study states.

Delta and Omicron coinfection is one of several concerns voiced by Paul Burton, MD, the chief medical officer at Moderna, to a panel of lawmakers in the United Kingdom.

Infection preventionists will be watching closely as the nation’s Top Court is expected to rule—perhaps within days—whether hospitals can mandate that their workers get the COVID-19 vaccine.

Just when should a health care professional return to work after a high-risk COVID-19 exposure? In a Q&A, Sharon Ward-Fore, MS, MT(ASCP), CIC, FAPIC, explains the CDC’s changing recommendations.

Bug of the Month helps educate readers about existing and emerging pathogens of clinical importance in healthcare facilities today.

As the government rolls out 500 million rapid at-home antigen tests, results of a small study suggest that those tests will produce false-negatives that will enhance Omicron’s spread.

Published: November 11th 2021 | Updated: November 19th 2021

Published: October 12th 2020 | Updated: November 12th 2020

Published: December 9th 2020 | Updated: December 29th 2020

Published: December 29th 2021 | Updated: February 25th 2022

Published: October 4th 2021 | Updated: October 6th 2021

Published: February 15th 2022 | Updated: February 25th 2022